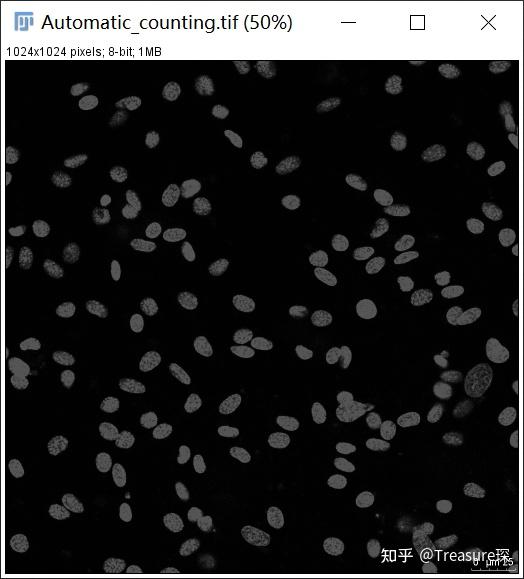
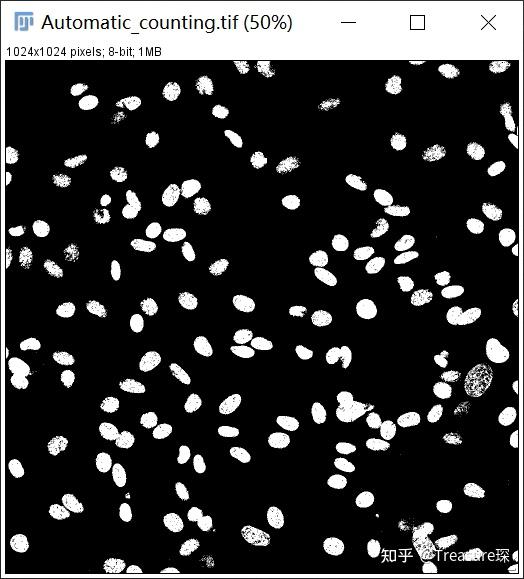
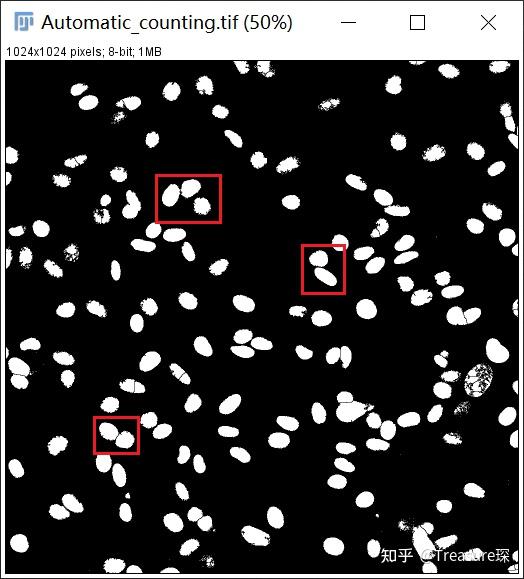

ImageJ实用技巧——自动细胞计数(解放双手篇)
操作视频更新:
 操作视频-ImageJ自动细胞计数
https://www.zhihu.com/video/1166822620372144128
操作视频-ImageJ自动细胞计数
https://www.zhihu.com/video/1166822620372144128
对于生物狗和密集恐惧症患者来说, 手动数细胞 是一个极其无聊以及耗费精力的工作。


扯远啦~上一篇为大家介绍了ImageJ的安装,以后的文章我会以 实际应用 的方式,解释ImageJ各种目录以及功能。
这是解放双手篇的第一篇——利用ImageJ实现自动细胞计数。我也会介绍一下多种细胞手动计数的方法。
利用ImageJ进行自动细胞计数的工作流程(Workflow):

在进行自动细胞计数之前,如果你的图像是荧光图像(信号是亮的,背景是黑的),
需要对ImageJ进行初始设置 (Process -> Binary -> Options) :

勾选Black background。
一、自动细胞计数
1、打开想要处理的图像(File-Open,或者将图片直接拖动到菜单栏)

我们的目标是:自动对DAPI染色的细胞核进行计数,得到细胞核的总数。
2、将图像转为8-bit(Image-Type-8-bit)
RGB格式简介: 一般彩色的荧光图片都是RGB格式的。RGB代表 红、绿、蓝 三种颜色,可以通过这 三种颜色的叠加 得到各式各样的颜色。
而RGB的每个通道各有 256级亮度 ,用数字表示为从0、1、2...直到255。在0时最弱,而在255最亮。
例如,纯红色的R值为255,G值为0,B值为0,即(255,0,0)。 灰色的R、G、B三个值是相等的(除了0和255);黑色的R、G、B都为0,;白色的R、G、B都为255。
按照计算,256级的RGB色彩总共能组合出约1678万种色彩,即256×256×256=16777216。也称为24位色(2的24次方)。

当我们把一个RGB图像,转换为8-bit图像时,其实就是来了一个简单的缩放 。使用以下公式转换为灰度:
灰色=(红色+绿色+蓝色)/ 3
转换为8-bit之后,每个像素仅仅只有一个通道,有256级灰度,即0~255,表示亮度从深到浅,对应图像中的颜色为从黑到白。
注意:如果你的图像在保存时,已经保存成单通道了(8-bit,16-bit),不需要进行这一步。这一步是为了后面,设置Threshold。
16-bit的图像可以直接进行Threshold,不用转成8-bit,否则会有亮度信息的损失。
3、调整阈值,去除背景,选中细胞核(Image-Adjust-Threshold)

注意选择Red来进行表征 ,所以变为红色的区域就是已经选中的区域。
注意背景是黑的,所以要勾选Dark Background!
这时候可能需要进行两项操作:
(1)如果图像带有比例尺:拖动调节阈值的上限可以去除比例尺 (因为自动计数可能会把比例尺也当做细胞来统计)

(2)如果自动阈值效果不好:换拖动调节阈值的下限,可以增加选中区域 ,但要注意在选中细胞核的同时,尽可能少的减少背景。或者选择不同的自动阈值算法。
拖动完成后点击Apply ,图片转为非黑即白的二值化图片:
5、填补细胞核的空隙(Process-Binary-Fill Holes)
在调节阈值减少背景的同时,可能细胞核的一些不均匀部分也被减弱了,可以填补空隙,使得细胞核变成实心球形:

6、打断细胞核的重叠部分(Process-Binary-Watershed)
细胞密度比较大时,通常会有细胞重叠或者贴近的情况。可以利用Watershed自动识别重叠部分,并将两个细胞核分离开来:
7、自动分析、计数颗粒(Analyze-Analyze Particles)

出现Analyze Particles界面,通过不同的情况设置参数, 最重要的是红框中的参数 。
Size:300-Infinity——指分析颗粒面积大于300(一定注意这里的单位是pixel),一直到无穷大的颗粒。( 根据细胞大小,以及结果好坏来更改 )
Circularity:0.00-1.00——指圆度,可以根据细胞形状,调整需要的圆度,1.00为标准圆。
Exclude on edges——处于边缘的颗粒不计入
设置完成后,点击OK,即出现以下结果:

可以看到最后统计出的细胞核数为141,且每个细胞核的面积也在Results中显示出来。 可以放大检查原图中是否有多数或者漏数的细胞。
注意:自动计数并不是完全准确的,如果发现自动计数与实践明显出现偏差,出现多数或者漏数,需要优化阈值(Threshold)和颗粒尺寸的判断标准(Size以及Circularity)。并且形状无规则的细胞,例如神经细胞,不适于自动计数,需要手动计数,所以接下来介绍一下利用ImageJ进行手动细胞计数。
二、手动细胞计数
主要有两种方法:
1、Multi-point工具

双击可以更改点的形态、颜色和大小。使用的时候直接点击细胞,就会自动的标号。但对于多种细胞类型分别计数,并不是很便捷。

2、Cell Counter插件
这就显示出Fiji,相对于传统的ImageJ的优势了。 基本能用上的插件,都已经包含在程序中, 只需要搜索即可。例如我们在搜索框中输入:Cell,即可出现Cell Counter这个插件的选项。选中后,点击Run即可。

然后就会出现Cell Counter插件的界面,可以对多种细胞进行计数,并且在同一图像中显示出来。具体的应用其实非常简单,在这里就不再赘述了。

细胞自动计数和手动计数,大概介绍完了。如果想熟练掌握,可以随便百度一张红血球计数板的照片,按照上面的步骤一步一步操作即可。
如果对于ImageJ使用有什么问题可以私信我,或者给我发邮件:zhaoyc9@163.com
更多教程可以关注我的专栏:
希望对大家有帮助~

